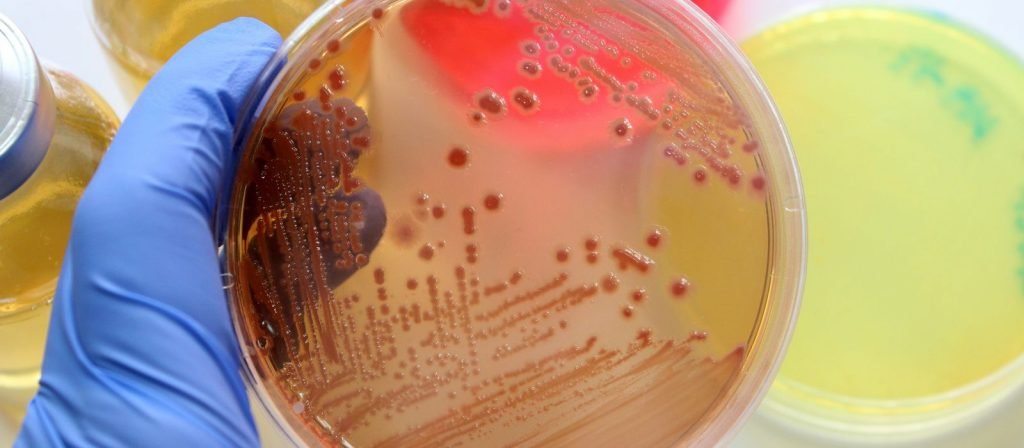

O que é Triptona? Saiba a sua Importância para a Microbiologia.
O ágar triptona vem sendo usado com sucesso por décadas para desenvolver e manter culturas biológicas. Mas o que exatamente é o ágar triptona e como ele revolucionou a cultura em meio sólido? Descubra neste artigo como essa nova tecnologia tem redefinido os métodos de experimentação e testes laboratoriais, trazendo maior precisão e resultados obtidos!
O ágar triptona é um meio não seletivo utilizado para a determinação da motilidade e capacidade de fermentação de bactérias aeróbias e anaeróbias. É recomendado para Clostridia, espécies de Bacillus, Micrococci, bacilos entéricos e outros organismos não proliferativos. Este meio também serve como uma base que, com suplementos, pode ser usada para uma ampla variedade de microrganismos exigentes.
Composição da Triptona
A Triptona é obtida a partir da digestão enzimática da caseína, proteína principal do leite. Durante esse processo, enzimas proteolíticas (como a tripsina) quebram a caseína em fragmentos menores, resultando em uma mistura altamente nutritiva para microrganismos.
Sua composição típica inclui:
-
Peptídeos e polipeptídeos solúveis – cadeias curtas de aminoácidos facilmente assimiláveis pelas células.
-
Aminoácidos livres – especialmente o triptofano, essencial para testes microbiológicos como o de produção de indol.
-
Peptona de caseína – base proteica que fornece nitrogênio orgânico de rápida utilização.
-
Compostos minerais traço – cálcio, fósforo e outros micronutrientes remanescentes da proteína original.
Essa composição garante que a Triptona seja uma fonte rica e equilibrada de nitrogênio, carbono e energia, atendendo às necessidades de uma ampla gama de microrganismos.
Qual a função do Ágar triptona?
A Ágar triptona é um tipo de agar usado na cultura em meio sólido. É uma mistura de duas proteínas, caseína e globulina, que fornece um meio ideal para o crescimento bacteriano. A agar triptona é amplamente utilizada na microbiologia e na biologia celular, pois permite um controle preciso do ambiente de cultivo. Além disso, a agar triptona é muito versátil e pode ser usada para diferentes fins, como o cultivo de bactérias láticas ou mesmo de fungos.
Muitos estudos demonstraram que a adição de ágar triptona ao meio de cultura aumenta significativamente o número de células que sobrevivem e se multiplicam. No entanto, até recentemente, os cientistas não tinham muita compreensão sobre como esse componente do meio de cultura funcionava.
A importância da triptona em microbiologia
A triptona é um dos ingredientes mais importantes em microbiologia. É um peptídeo de cadeia curta que contém um aminoácido com side chain amida, que é responsável por sua atividade biologicamente ativa. A triptona é usada na pesquisa de bactérias e fungos, bem como na identificação e controle de microrganismos.
A triptona é usada para estimular o crescimento e diferenciação de células microbianas, possibilitando o estudo de características do microrganismo. Ela também pode ser usada como meio nutritivo para estimular o crescimento de microrganismos, sendo ideal para a realização de testes de identificação e quantificação. Por sua vez, a triptona serve como fonte de energia na produção industrial de alguns antibióticos bactericidas.
Além disso, a triptona também tem sido empregada em estudos sobre resistência bacteriana a drogas antimicrobianas. Ela foi usada para avaliar a sensibilidade às sulfonamidas e outros antibióticos. Com isso, é possível identificar os mecanismos que levam à resistência destes fármacos
Quais os benefícios da Triptona
A Ágar triptona é um ingrediente comumente usado na preparação de meios de cultura bacteriana. É derivado da proteína caseína e contém aminoácidos essenciais, vitaminas e sais minerais. O ágar triptona é uma fonte de energia para as células bacterianas em seu processo de crescimento.
A triptona ágar é um dos componentes da mistura de meios de Lowenstein-Jensen, que é utilizada no cultivo microbiano para a detecção e identificação de bactérias acid-fast. A presença dessa substância nos meios de culture facilita a visualização das bactérias através do microscópio, uma vez que elas ficam “presas” no gel. Dessa forma, o ágar triptona tornou-se uma ferramenta indispensável para o diagnóstico bacteriológico.
FAQ: A Importância da Triptona para a Microbiologia
1. O que é Triptona?
A Triptona é um hidrolisado enzimático da caseína, proteína do leite. Ela contém peptídeos e aminoácidos solúveis que servem como fonte essencial de nutrientes para o crescimento de microrganismos.
2. Qual a composição da Triptona?
A Triptona é composta principalmente por:
Peptídeos e polipeptídeos solúveis
Aminoácidos livres, com destaque para o triptofano
Peptona de caseína (nitrogênio orgânico)
Sais minerais em pequenas quantidades
Essa composição garante alto valor nutritivo e biodisponibilidade.
3. Para que serve a Triptona em microbiologia?
A Triptona fornece nitrogênio e carbono facilmente assimiláveis, fundamentais para o crescimento de bactérias e fungos em meios de cultura. Também é usada em testes bioquímicos, como o teste de indol.
4. Em quais meios de cultura a Triptona é usada?
Ela é ingrediente-chave em meios clássicos como:
Luria-Bertani (LB Broth)
Tryptic Soy Broth (TSB)
Caldo Nutriente
Meio de Indol
5. Por que a Triptona é importante em testes de indol?
O teste de indol avalia a capacidade de algumas bactérias de degradar triptofano. Como a Triptona é rica nesse aminoácido, é indispensável para esse diagnóstico microbiológico, especialmente em Enterobacteriaceae como E. coli.
6. A Triptona pode ser substituída por outras fontes proteicas?
Sim, existem alternativas como peptona de soja e extrato de levedura, mas nenhuma possui a mesma riqueza em triptofano que a Triptona, tornando-a única para determinados testes e meios.
7. Quais são as aplicações industriais da Triptona?
Além do uso laboratorial, a Triptona é aplicada em processos de fermentação para produção de antibióticos, enzimas, proteínas recombinantes e até bebidas fermentadas.
8. Qual a diferença entre Triptona e Peptona?
A Triptona é obtida especificamente da caseína hidrolisada pela enzima tripsina. Já a Peptona pode ser derivada de diferentes proteínas (carne, soja, gelatina) e por diversos métodos enzimáticos ou ácidos.
9. A qualidade da Triptona influencia os resultados laboratoriais?
Sim. Triptonas de baixa pureza podem comprometer o crescimento microbiano e gerar resultados inconsistentes. Por isso, é fundamental utilizar fornecedores confiáveis.
10. Onde comprar Triptona para microbiologia?
A Splabor oferece Triptona de alta qualidade, indicada para laboratórios de microbiologia, pesquisa e indústria. 👉 Solicite uma cotação agora mesmo
.
Conclusão
A Ágar triptona é um produto revolucionário que está mudando a forma como as pessoas cultivam em meio sólido. O ágar triptona foi desenvolvido para fornecer uma base de meio sólido mais segura e consistente do que a agarosa, que era o material de base de meio sólido utilizado até então. Além disso, o ágar triptona é mais fácil de usar e manipular do que a agarosa, tornando-se uma escolha popular entre os cultivadores em meio sólido. Solicite seu orçamento de triptona
Não se esqueça de deixar aqui um comentário sobre a sua impressão ao ler o material.
AVISO DE DIREITOS AUTORAIS: Todo o material deste blog, sendo proibida toda e qualquer forma de plágio, cópia, reprodução ou qualquer outra forma de uso.
Qualquer dúvida técnica sobre os equipamentos contidos no portfólio SPLABOR, entre em contato com o Departamento de Vendas (sp@splabor.com.br)

A Splabor é uma empresa líder no ramo de fabricação de equipamentos para laboratório, especializada em oferecer uma ampla variedade de equipamentos para laboratórios, materiais e produtos para laboratório de alta qualidade.